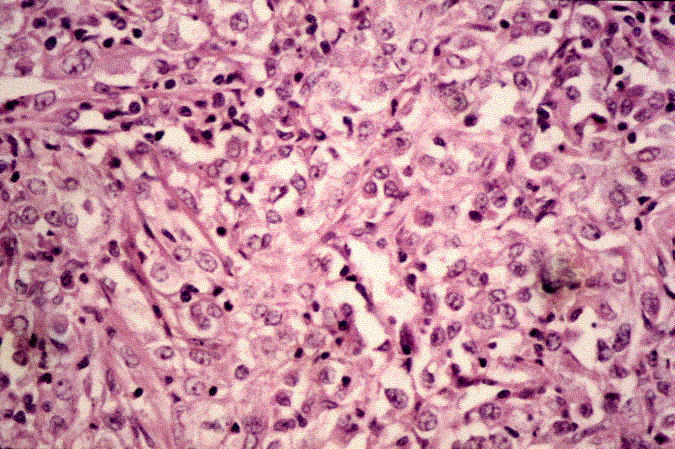

|
Home
Coping With Cancer
Kidney Cancer
Risk Factors/Causes
Signs & Symptoms
Diagnosis
Stage Info
Surgical Treatments
Non-Surgical Treatments
Cancer Immunotherapy
Recurrnet Kidney Cancer
Types of Kidney Cancer
My Father
Sources
|
Non-Surgical Treatments
(Cancer Under a Microscope)
If surgery is not your thing, thanks to technology, there are nonsurgical treatments as a substitute. There is chemotherapy which uses chemical agents to kill the cancer cells in the body. Unfortunately, RCC has proven to be particularly resistant to chemotherapy. The use of radiation to shrink and kill cancer cells is used to treat some patients. It is often used as a follow-up treatment is needed. This also has a relatively low success rate. Other treatments are hormone therapy which remains to future research, and biological therapy to boost, restore, or direct the patient’s immune system to fight RCC in the same way it would fight an infection. and chemo biological therapy. Some patients will try one of these treatments before jumping into serious surgery. It really depends on the cancer and how serious and far along in stage it is. (http://www.oncologychannel.com/kidneycancer)
|